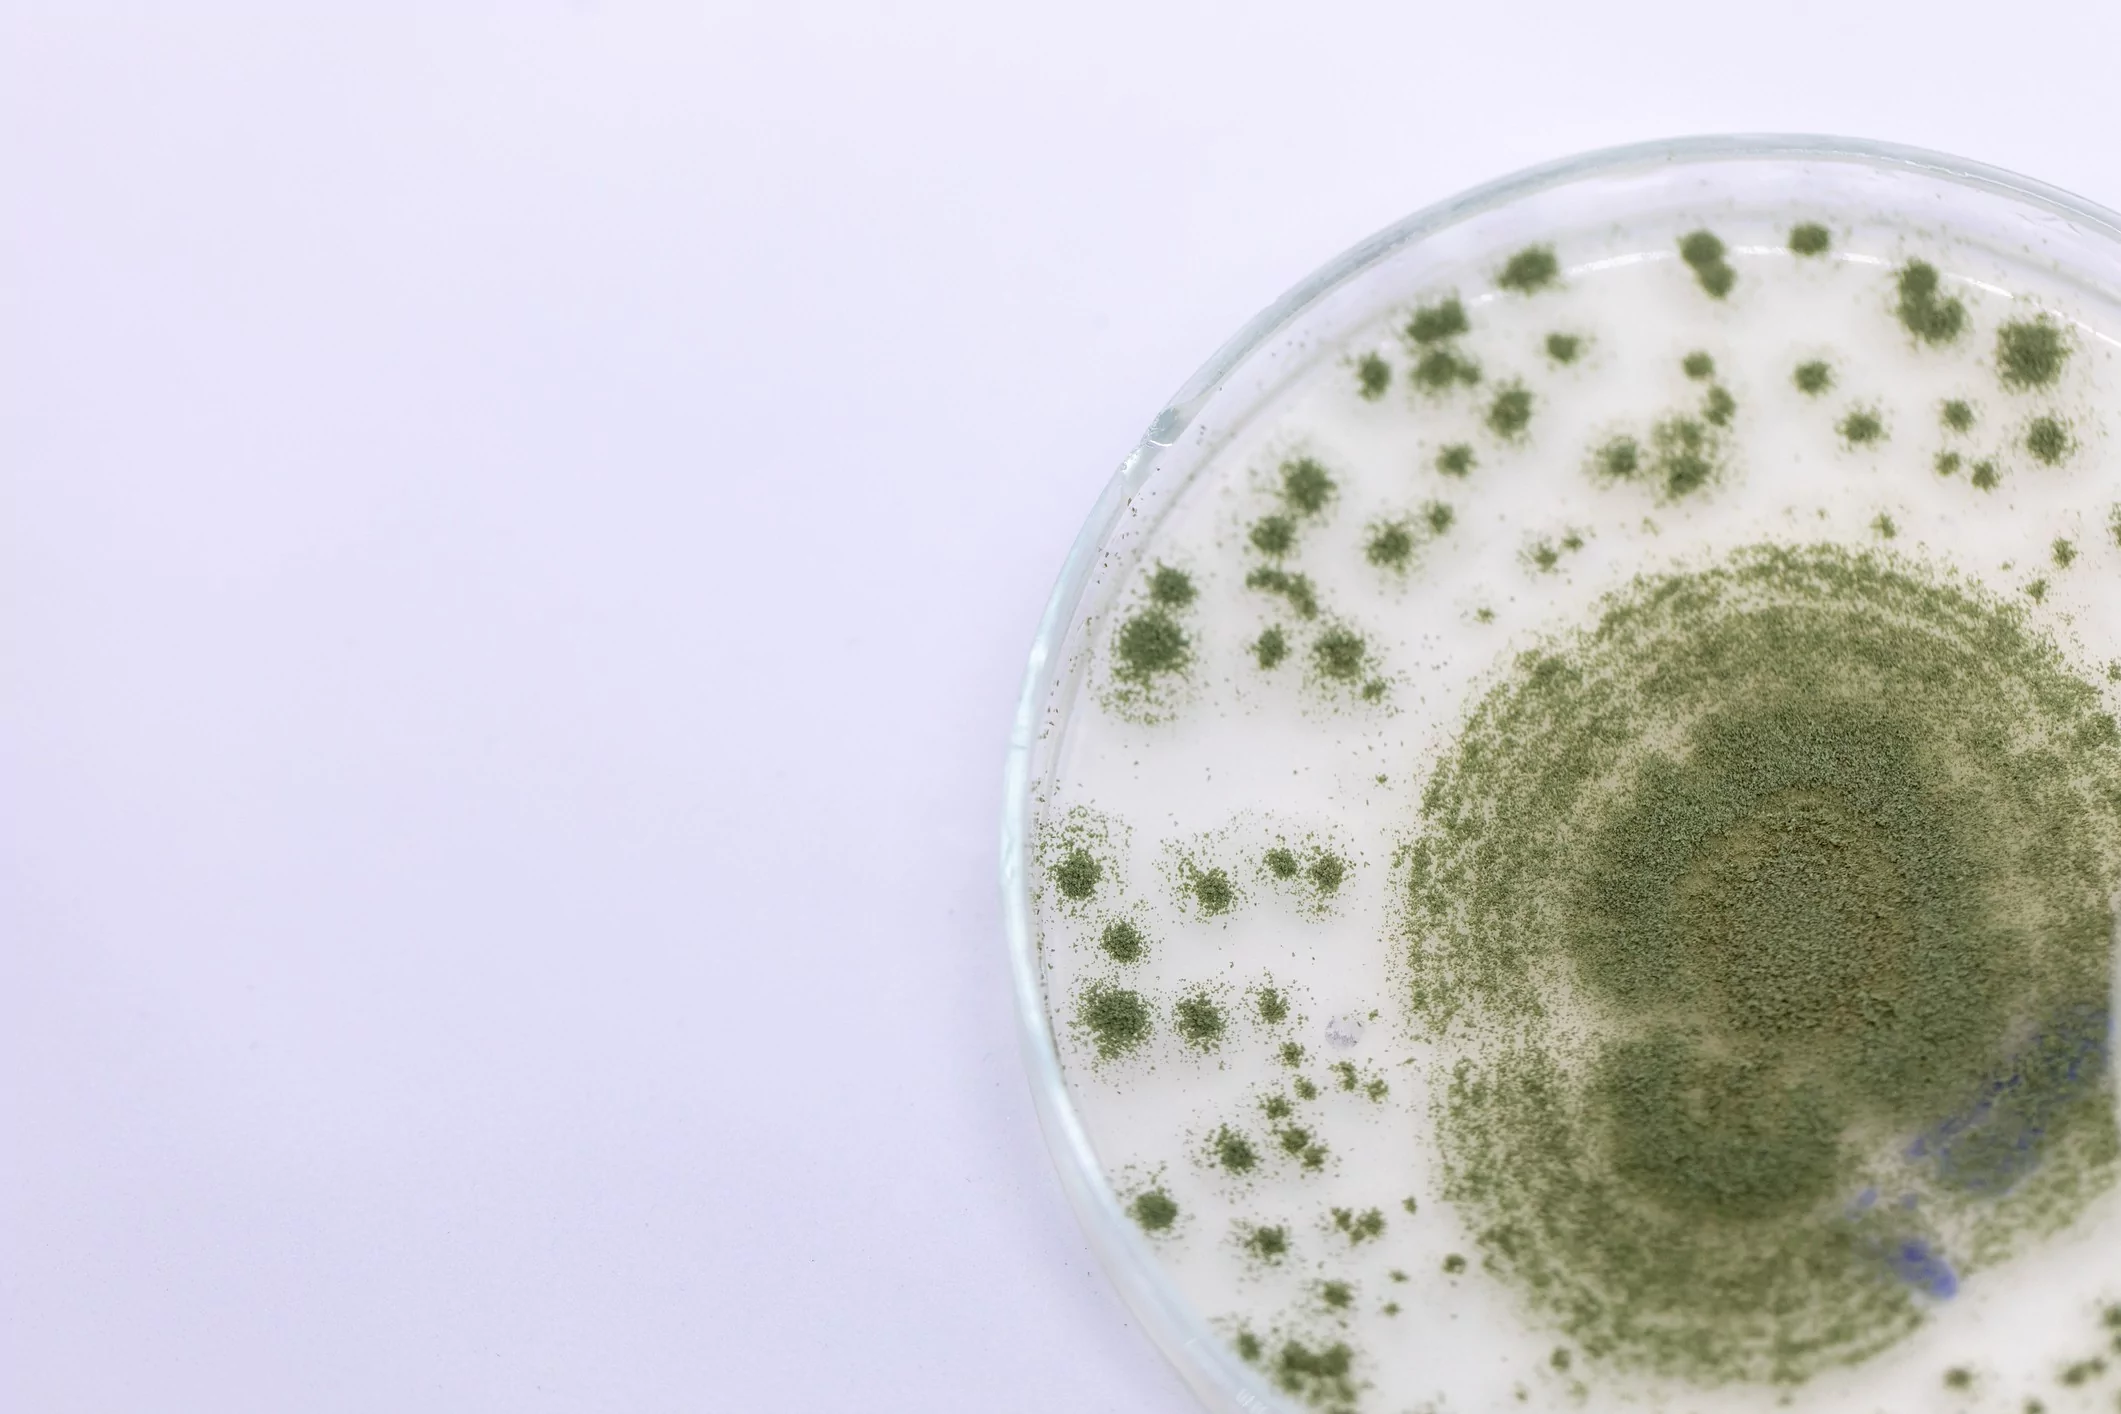
Aspergilose - Imunologia

EP
CLÍNICO
Aspergilose – Imunologia
Categorias: Clínico, Ensaio de Proficiência, Imunologia / Proteínas
- Aspergillus spp. Total
- Aspergillus fumigatus IgA
- Aspergillus fumigatus IgG
- Aspergillus fumigatus IgM
- Aspergillus fumigatus Total
Ensaio de Proficiência
- Soro humano liofilizado de 100uL.
- Qualitativo.
Programas disponíveis:
- Aspergilose – Imunologia (2 itens x 4 rodadas) – EPIAA24 | EP535
Programas Relacionados
-
CL
Aspergillus spp. – Biologia Molecular
O programa contempla técnicas moleculares baseadas em PCR.As amostras contém genoma completo do microrganismo. Detecção de Aspergillus spp.
EPCLÍNICO